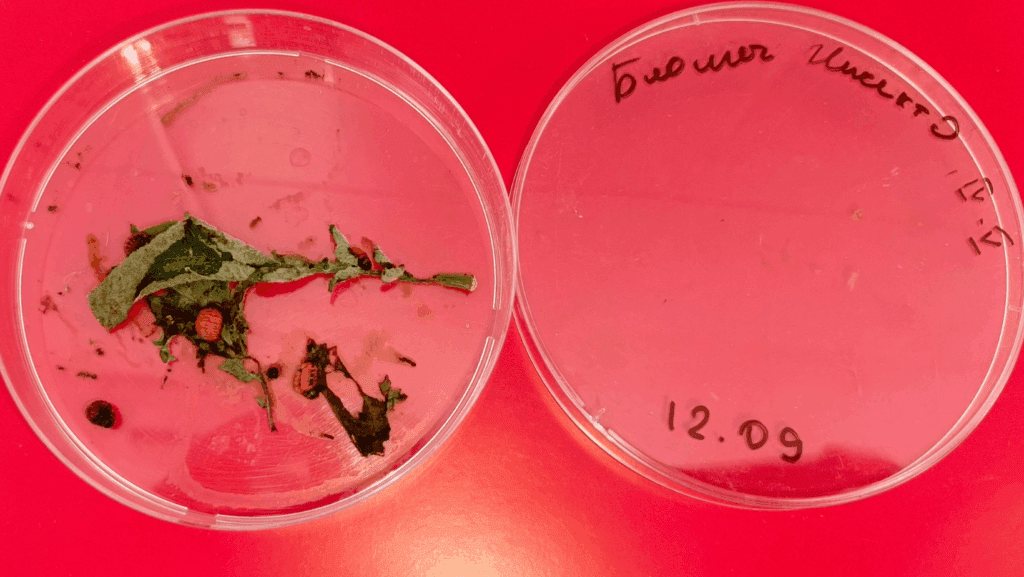

Новый биоинсектицид в портфеле: БиоМеч Инсекто. Применение и результаты испытаний
В нашем портфеле появилась новинка: биологический инсектицид БиоМеч Инсекто. В этой публикации мы покажем результаты предрегистрационных испытаний, а также расскажем об особенностях препарата и возможностях его совместного применения с химическими инсектицидами.
БиоМеч Инсекто, П — биоинсектицид, комбинирующий два энтомопатогенных микроорганизма: бактерию Bacillus thuringiensis var. kurstaki (штамм HG 207, 1×109 КОЕ/г) и гриб Beauveria bassiana (штамм HG 208, 1×106 КОЕ/г). Препарат реализуется в форме порошка и предназначен для защиты сельскохозяйственных культур от комплексных вредителей. Его действие основано на кишечном эффекте токсинов Bt и контактном заражении грибом Bb, что обеспечивает широкий спектр эффективности.
Результаты дорегистрационных испытаний
Испытания проводились с 2022 по 2024 годы на различных культурах: соя, томат, картофель, лук, зернобобовые, рапс и цветная капуста и были направлены на борьбу с широким спектром вредителей, например, соевая плодожорка, капустная моль, совки, колорадский жук, пилильщики.

Средняя эффективность по годам и вариантам препарата БиоМеч Инсекто по культурам.
Испытания подтвердили высокую эффективность биопрепарата с показателями до 100% в оптимальных условиях и устойчивую эффективность (свыше 60%) в менее благоприятных условиях
Следующая диаграмма наглядно демонстрирует, что препарат показывает стабильно высокую эффективность (81-99%) против всех исследованных вредителей из отряда чешуекрылых (Lepidoptera) и перепончатокрылых (Hymenoptera).
Топ-вредители по эффективности:
- Максимальная эффективность (95-99%): рапсовый пилильщик (99,0%), гороховая плодожорка (96,0%)
- Высокая эффективность (85-90%): луковая моль (85,0%)
- Хорошая эффективность (81-85%): капустная совка (84,3%), хлопковая совка — 83,3%, соевая плодожорка — 83,0%, люцерновая совка — 82,5%, капустная моль — 81,5%, картофельная моль — 81,0%

Ключевые выводы
Спектр действия: Препарат эффективен против широкого спектра экономически значимых чешуекрылых вредителей (моли, совки, плодожорки) и пилильщиков.
Стабильность: Средняя эффективность по всем вредителям составляет 86,3%, что свидетельствует о стабильном действии двухкомпонентной композиции Bacillus thuringiensis + Beauveria bassiana.
Особенности: Наиболее высокая эффективность отмечена против вредителей бобовых и рапса (96-99%), что делает препарат особенно перспективным для этих культур.
Важно отметить, что представленные показатели являются усредненными по всем регионам испытаний. Фактическая эффективность в конкретных условиях может варьировать в зависимости от климатических факторов.


Особенности применения на основе многолетних исследований
Особенности:
- Климатическая чувствительность: активность микроорганизмов снижается при температурах выше +25°C и под воздействием сильного солнечного света.
- Более медленное в сравнении с химическими инсектицидами скорость действия: гибель вредителей наступает через 4-8 дней после обработки.
- Совместимость: ограничена с некоторыми фунгицидами и бактерицидами при баковом смешивании.
- Хранение: препарат требует строгого соблюдения температурного режима (-30°C до +30°C) для сохранения активности до 5 лет.
Рекомендации по применению:
- Выбор более оптимальных условий обработок: рекомендуемая температура воздуха от +10°C до +25°C. Рекомендуется проводить обработку в вечернее время для уменьшения фотодеградации.
- Внедрение интегрированных программ защиты растений с использованием совместимых баковых смесей с химическими инсектицидами или чередованием биоинсектицида и химических средств.
- Использование адъювантов для повышения устойчивости микроорганизмов, например Агропол Супер или Агропол Эмульс
Ключевой тактикой для успешного применения БиоМеч Инсекто является его совместное применение с химическими инсектицидами, рассмотрим преимущества и сложности такого подхода, а также рекомендации по совместному использованию.
Преимущества:
- Синергетический эффект: Биологические и химические активные вещества обеспечивают более широкий спектр действия и усиленную борьбу с вредителями.
- Антирезистентность: Разные механизмы воздействия помогают замедлить или предупредить выработку резистентности у вредителей.
- Снижение доз химических инсектицидов: Возможность уменьшения дозировки химических препаратов на 20-30% при сохранении уровня контроля, но не ниже дозировки, обозначенной в Свидетельстве о государственной регистрации (СГР) препарата.
- Сочетание быстрого и пролонгированного эффекта: Быстрое действие химии дополняется пролонгированным эффектом биопрепарата
Сложности:
- Физико-химическая несовместимость: Риск коагуляции или инактивации биокультуры при смешивании с ХСЗР.
- Необходимость контроля и коррекции рН рабочего раствора, так как излишне кислая или щелочная среда может влиять на жизнеспособность биоинсектицида (оптимум pH 6,0-7,0)
Рекомендации при совместном использовании с химическими пестицидами:
- Предварительное тестирование баковых смесей на предмет физико-химической совместимости.
- Использование pH корректора, например Агропол Баланс
- Рекомендуется как можно скорее вырабатывать получившийся рабочий раствор, не оставляя его на долгое время. Если раствор всё же остался, обязательно периодическое перемешивание.
Совместимость с группами химических инсектицидов:
- БиоМеч Инсекто + пиретроиды (альфа-циперметрин, дельтаметрин)
- БиоМеч Инсекто + неоникотиноиды (имидаклоприд, тиаметоксам)
- БиоМеч Инсекто + фосфорорганические соединения
БиоМеч Инсекто, П — является эффективным биоинсектицидом с доказанной высокой эффективностью против широкого спектра вредителей. Несмотря на определённые особенности, интеграция с химическими инсектицидами усиливает общий эффект и расширяет возможности применения на различных культурах. Препарат рекомендуется использовать как часть комплексных программ защиты растений с учетом условий применения и совместимости.